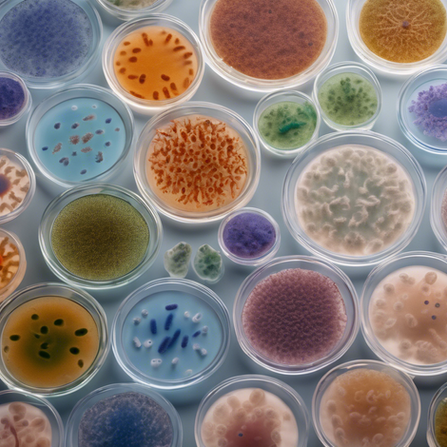
Antimicrobial Resistance

The González‑Juarbe Lab at the University of Maryland



The González‑Juarbe Lab at the University of Maryland
Overview
We examine how bacteria and viruses interact with the body, applying molecular, cellular, and genomic approaches to identify the mechanisms that contribute to severe and persistent infections.
What We Do
Our lab investigates how infections affect the lungs, gut, and immune system, and how harmful microbes use these changes to cause more serious disease. We study how infections disrupt the microbiome and alter key proteins in different organs, using both cell‑based and animal models to understand these effects. Our team also develops and tests new treatment approaches, including antimicrobial proteins, engineered viruses, and tools from synthetic biology. By examining how pathogens interact with the body and how the body responds, we work to uncover the processes that drive complex, life‑threatening infections, fostering a collaborative environment that encourages innovation and discovery.
Why Our Work Matters?
Severe infections can lead to long-term health issues, especially when pathogens are resistant to treatment or trigger harmful immune reactions. By highlighting how infections disrupt key biological systems, our research aims to demonstrate the importance of their contribution to improving diagnostics and targeted therapies. We aim to develop innovative treatment approaches for infectious diseases and certain cancers. Our goal is to turn scientific insights into strategies that improve patient outcomes and long-term health.
Research Areas that Advance
Our Understanding of Disease

Meet the Principal Investigator
Dr. Norberto González‑Juarbe is a microbiologist and immunologist. He studies how bacterial pathogens cause disease. His work looks at how microbes attach, grow, and damage tissues during infection. He uses this knowledge to find new ways to prevent and treat severe bacterial and viral illnesses. His research also explores how infections disrupt the lungs, gut, and immune system. It shows how pathogens exploit these changes to worsen disease. By combining molecular, cellular, and genomic methods, he leads efforts to create innovative therapies. These include antimicrobial proteins, engineered viruses, and other synthetic-biology tools to fight life-threatening infections.
Media Coverage
New method for detecting ancient DNA in art.
​
Visit our Media page to learn more about our latest da Vinci Project and other news.

Featured Publications